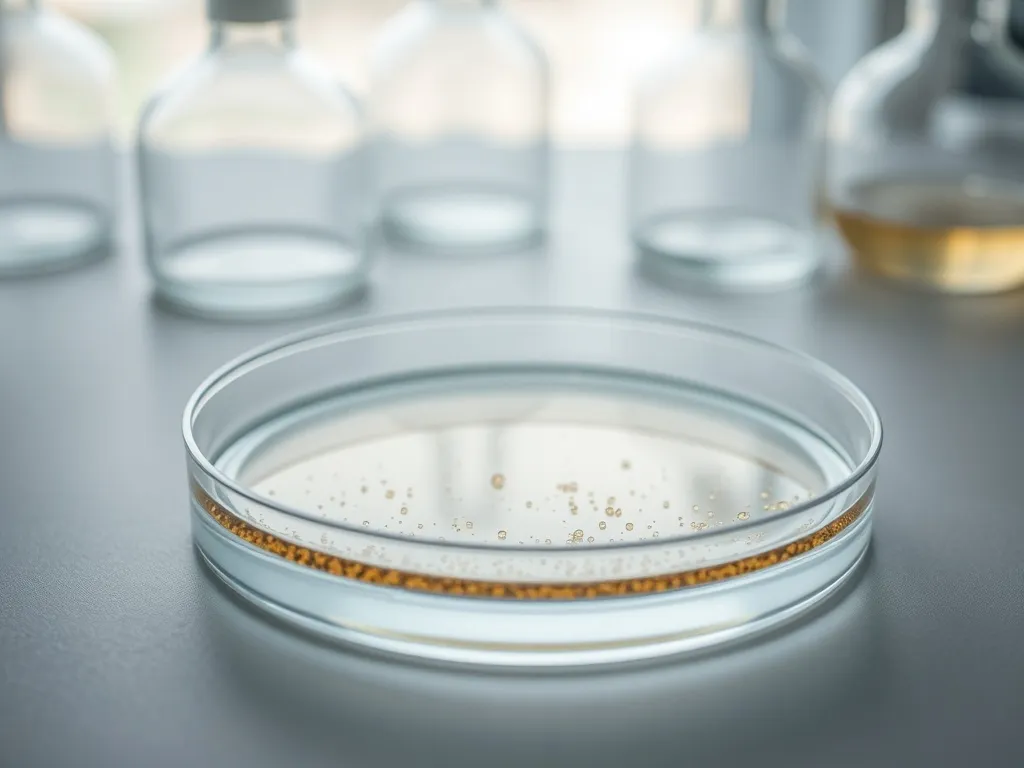
Warstwa dyspersyjna – co to jest i jak działa?

Myślisz, że warstwa dyspersyjna to po prostu „niedoschnięty” lakier? Z tego tekstu dowiesz się, czym naprawdę jest ta lepka powłoka i jak z nią pracować. Poznasz też różnice między topem z warstwą dyspersyjną a topem no wipe, żeby świadomie wybrać produkt do swojego manicure.
Co to jest warstwa dyspersyjna?
Warstwa dyspersyjna, nazywana też warstwą lepką lub inhibicyjną, to cienka, klejąca powłoka, która pojawia się na powierzchni bazy, koloru, żelu, akrylożelu lub topu po utwardzeniu w lampie UV/LED. W dotyku jest tłusta i „ciągnąca się”, przez co wiele osób traktuje ją jak błąd w stylizacji. W rzeczywistości to naturalny efekt procesu polimeryzacji produktów światłoutwardzalnych i bez niej manicure nie trzymałby się tak dobrze na płytce.
Podczas utwardzania w lampie tylko część cząsteczek polimeru łączy się w trwałą sieć. Te, które znajdują się bliżej powietrza, reagują wolniej i pozostają częściowo nieutwardzone, tworząc właśnie lepki film na powierzchni. To nie jest objaw słabej lampy ani „niedoschniętego lakieru”, tylko normalny etap w budowie stylizacji hybrydowej czy żelowej.
Warstwa dyspersyjna nie jest cechą naturalnej płytki paznokcia – to efekt użycia produktów światłoutwardzalnych, który decyduje o przyczepności i trwałości stylizacji.
Jaką rolę pełni warstwa dyspersyjna?
Najważniejsze zadanie tej warstwy to wzmocnienie połączenia pomiędzy wszystkimi produktami, które nakładasz na paznokieć. Warstwa lepka działa jak delikatny „klej”, który zwiększa adhezję kolejnej warstwy, dlatego baza lepiej łączy się z naturalną płytką, kolor z bazą, a top z kolorem. Stylizacja tworzy wtedy zwartą całość i jest bardziej odporna na odpryski oraz odwarstwienia.
Druga istotna funkcja to zapewnienie elastyczności całej konstrukcji. Produkty z dyspersją (szczególnie elastyczne bazy i topy) lepiej „pracują” na słabych, giętkich paznokciach. Taka stylizacja mniej pęka przy codziennych obciążeniach, bo lepka warstwa kompensuje drobne ruchy płytki i rozkłada napięcia w masie productu.
Dlaczego warstwa lepka jest tak ważna przy zdobieniach?
Warstwa dyspersyjna to idealne podłoże dla efektów specjalnych i biżuteryjnych zdobień. Drobinki pyłków, folie transferowe czy płatki dekoracyjne mocno „łapią się” tej powłoki i pozostają w niej zatopione. Dzięki temu możesz tworzyć stylizacje z Efektem Syrenki, efektami holo, Metal Manix czy Pixel Effect bez ryzyka, że ozdoby odpadną po kilku dniach.
Na warstwie lepkiej świetnie trzymają się też m.in. blingi, delikatne nitki dekoracyjne czy płatki typu Flame Effect. Wystarczy wetrzeć lub przyłożyć ozdobę do dyspersji, a następnie zabezpieczyć ją cienką warstwą topu. Cały proces trwa chwilę, a ilość możliwych efektów jest ogromna i łatwo ją dopasować do stylu konkretnej klientki.
Jak działa warstwa dyspersyjna podczas stylizacji?
Praca z warstwą dyspersyjną zaczyna się już na etapie bazy. Po utwardzeniu pierwszej warstwy produktu nie usuwa się lepkości, ponieważ to właśnie ona poprawia przyczepność kolejnych kroków stylizacji. Im lepiej rozumiesz to zjawisko, tym łatwiej opanujesz trwałe, estetyczne hybrydy i żele.
Różne produkty, nawet tej samej marki, mogą zostawiać warstwę o innej grubości i stopniu lepkości. Wpływa na to zarówno ich skład, jak i grubość nałożonej warstwy, czas i moc utwardzania. Dlatego warto obserwować, jak zachowuje się konkretny żel budujący, baza hybrydowa czy top z warstwą dyspersyjną i na tej podstawie dopasowywać technikę pracy.
Kiedy nie usuwać warstwy dyspersyjnej?
Są etapy manicure, na których usuwanie dyspersji zwyczajnie osłabia stylizację. Po utwardzeniu bazy pozostawienie lepkości wzmacnia połączenie z kolorem, a po pierwszej warstwie koloru pomaga „złapać” kolejną lub top. Brak warstwy lepkiej między warstwami może skutkować gorszą przyczepnością lakieru hybrydowego i szybszymi odpryskami.
Nie usuwasz też dyspersji, kiedy planujesz zdobienia na produkcie – na przykład przy wcieraniu pyłków, odbijaniu folii transferowej albo wtapianiu drobnych ozdób w masę. Warstwa lepka zapewnia wtedy mocne zakotwiczenie dekoracji i zapobiega ich przesuwaniu podczas pracy.
Kiedy warstwa dyspersyjna może przeszkadzać?
Zdarza się, że lepkość jest zbyt obfita i zaczyna utrudniać dalsze etapy. Nadmiar dyspersji potrafi spowodować ściąganie koloru z wolnego brzegu, tworzenie „oczek” w okolicy skórek albo rozlewanie lakieru. Dzieje się tak szczególnie wtedy, gdy nałożysz zbyt grubą warstwę bazy budującej lub używasz produktu, który z natury daje silnie lepką powłokę.
Warstwa lepka może też szkodzić narzędziom. Jeśli zaczniesz opracowywać żel frezem bez wcześniejszego usunięcia dyspersji, masa oblepi nacięcia i wrażenie będzie takie, jakby frez się stępił. Podobny problem pojawia się przy pracy na produkcie, który nie utwardził się do końca – jest wtedy lepki, gumowy i zatyka wgłębienia. W takiej sytuacji lepiej sięgnąć po cleaner typu Wipe Off, usunąć lepkość i dopiero potem frezować.
Jak prawidłowo usuwać warstwę dyspersyjną?
Usuwanie warstwy dyspersyjnej wydaje się bardzo proste, a mimo to właśnie na tym etapie wiele stylistek traci połysk i gładkość topu. Najważniejsze jest dobranie właściwego płynu i techniki. Lepkość usuwa się wyłącznie na wybranych etapach, najczęściej dopiero po utwardzeniu ostatniej warstwy topu lub wtedy, gdy nadmierna dyspersja utrudnia dalszą pracę.
Do przemywania produktów światłoutwardzalnych używa się specjalnych płynów odtłuszczających, tzw. cleanerów do warstwy dyspersyjnej. Często zawierają alkohol izopropylowy, który skutecznie rozpuszcza lepki film i odsłania ostateczny połysk lub satynę. Nie stosuje się zmywaczy z acetonem, bo mogą zmatowić top i naruszyć jego strukturę.
Czym zmyć warstwę dyspersyjną?
Do usuwania dyspersji warto używać wyłącznie produktów przeznaczonych do tego celu. Niektóre firmy oferują klasyczne cleanery, inne preparaty wzbogacone o składniki pielęgnujące, które jednocześnie nadają płytce dodatkowy połysk. Możesz sięgnąć np. po płyny typu Shea Super Shine lub delikatne cleanery do poprawek w trakcie pracy.
Niektóre bazy mineralne 3w1 lub akrylożele w górnych formach wymagają przetarcia lepkości w trakcie budowy. Wtedy sięgasz po cleaner techniczny (np. Wipe Off) i dopiero potem opracowujesz kształt. Dzięki temu powierzchnia nie jest śliska, frezy się nie zapychają, a żel budujący zachowuje prawidłową strukturę.
Jak krok po kroku usuwać warstwę dyspersyjną?
Żeby nie zmatowić topu i nie osłabić stylizacji, usuwanie dyspersji powinno przebiegać według kilku prostych zasad:
- Poczekaj chwilę po wyjęciu dłoni z lampy, aby produkt „dopolimeryzował” i ostygł.
- Sięgnij po waciki bezpyłowe, które nie zostawią nitek na powierzchni paznokcia.
- Nasącz wacik niewielką ilością cleanera, nie przelewaj go płynem.
- Przetrzyj każdy paznokieć jednym ruchem – od skórek w kierunku wolnego brzegu.
- Nie wracaj zużytym wacikiem na kolejne paznokcie, za każdym razem użyj nowego.
- Unikaj zbyt mocnego tarcia, bo może to przygasić połysk i zmatowić top.
Warstwa dyspersyjna jest też najsilniej uczulającą częścią całego systemu produktów. Dlatego przy przemywaniu paznokci nie dotykaj skórek zużytym wacikiem i staraj się jednym płynnym ruchem ściągnąć lepkość z płytki. Zmniejszasz w ten sposób kontakt klientki z potencjalnym alergenem.
Przy topach z warstwą dyspersyjną lepiej odczekać około 2 minut po wyjęciu dłoni z lampy – zbyt szybkie przetarcie może częściowo zmatowić powierzchnię.
Top z warstwą dyspersyjną czy top no wipe?
Top hybrydowy to produkt, którego nie da się pominąć. Zabezpiecza kolor, wyrównuje powierzchnię, nadaje połysk lub mat i wpływa na trwałość całej stylizacji. Rynek oferuje ogromną liczbę topów, a jedno z najważniejszych kryteriów podziału to właśnie obecność warstwy dyspersyjnej lub jej brak.
Topy możesz podzielić także na błyszczące i matowe, z filtrami UV i bez, gęste i rzadkie, z dodatkowymi efektami dekoracyjnymi. Jednak pytanie „top z dyspersją czy no wipe?” wraca najczęściej, bo bezpośrednio wpływa na technikę pracy, czas zabiegu i możliwości zdobnicze.
Jak działa top z warstwą dyspersyjną?
Top z dyspersją to klasyka w stylizacji hybrydowej. Po utwardzeniu zostawia lepką powłokę, która po przetarciu cleanerem odsłania wysoki połysk lub mat. Ten typ topu jest elastyczniejszy, dzięki czemu bardzo dobrze sprawdza się na cienkich, miękkich paznokciach. Elastyczna konstrukcja mniej pęka, gdy płytka mocno pracuje.
Topy z warstwą dyspersyjną świetnie nadają się też do nakładania w dwóch warstwach, kiedy chcesz dodatkowo wyrównać strukturę lub zatopić wierzchnie zdobienia. Lepka warstwa między dwiema warstwami topu poprawia ich połączenie, a konstrukcja pozostaje spójna i odporna na odpryski.
Co wyróżnia top bez warstwy dyspersyjnej (no wipe)?
Top no wipe to produkt, który po utwardzeniu nie zostawia lepkości. Paznokcie wychodzą z lampy gotowe – nie trzeba ich przecierać, a stylizacja od razu ma pełen połysk lub satynę. Dzięki temu czas zabiegu skraca się, a zużycie cleanerów i wacików maleje, co ma znaczenie przy intensywnej pracy w salonie.
Topy bez dyspersji są zazwyczaj twardsze i bardziej błyszczące niż ich odpowiedniki z warstwą lepką. Idealnie sprawdzają się na twardych, mocnych paznokciach oraz przy biżuteryjnych zdobieniach – świetnie trzymają cyrkonie i ozdoby 3D, a także nadają się do wcierania wielu pyłków. Dodatkowo top no wipe jest często bezpieczniejszym wyborem dla klientów ze skłonnością do alergii, bo brak dyspersji ogranicza kontakt skóry z nieutwardzonymi cząsteczkami.
Kiedy lepiej wybrać top z dyspersją, a kiedy no wipe?
Dobór topu warto powiązać ze stanem płytki i rodzajem stylizacji. Przy bardzo cienkich, giętkich paznokciach lepiej sprawdzi się top z warstwą dyspersyjną, bo zapewnia elastyczność i daje możliwość budowania kilku warstw bez ryzyka pękania. To także lepszy wybór, kiedy planujesz bardziej zaawansowane, wielowarstwowe zdobienia.
Top no wipe to świetne rozwiązanie przy twardych paznokciach, prostych stylizacjach bez ozdób albo wtedy, gdy liczy się szybkość wykonania manicure. Trzeba jedynie pamiętać, że nie powinno się nakładać go w dwóch warstwach, bo druga może się odwarstwiać, a niektóre farbki czy stemple nie współpracują dobrze z jego gładką powierzchnią.
| Rodzaj topu | Najważniejsze cechy | Najlepsze zastosowanie |
| Top z warstwą dyspersyjną | Elastyczny, można nakładać kilka warstw, idealny pod zdobienia na lepko | Cienkie, giętkie paznokcie, stylizacje z pyłkami i foliami |
| Top no wipe | Twardszy, bardzo błyszczący, bez przemywania po utwardzeniu | Twarda płytka, szybkie manicure, biżuteryjne zdobienia |
| Top z filtrami UV | Chroni kolor przed żółknięciem i blaknięciem | Jasne i neonowe kolory, french, stylizacje letnie |
Jak uniknąć błędów przy pracy z warstwą dyspersyjną?
Problemy z warstwą lepką bardzo często wynikają z drobnych zaniedbań: zbyt grubej aplikacji produktu, skróconego czasu utwardzania lub źle dobranej lampy. Jeśli dyspersja jest nadmiernie lepka, kolor ściąga się z końcówek, a top matowieje po przetarciu, warto przeanalizować każdy krok stylizacji.
Na ilość i lepkość warstwy dyspersyjnej wpływa przede wszystkim skład produktu, grubość nałożonej warstwy oraz moc i czas pracy lampy UV/LED. Zbyt słaba lampa albo skracanie czasu utwardzania powodują, że wewnętrzne warstwy masy nie zdążą w pełni się utwardzić. Efektem jest gruba, gumowa, bardzo lepka powłoka, która utrudnia precyzyjną aplikację kolejnych produktów.
Jak pracować, żeby warstwa dyspersyjna była „sprzymierzeńcem”?
Żeby warstwa lepka pomagała, a nie przeszkadzała, wystarczy wdrożyć kilka prostych zasad w codziennej pracy:
- Stosuj produkty jednej lub dobrze dobranej marki, żeby uniknąć niepożądanych reakcji między warstwami.
- Nakładaj cienkie, równomierne warstwy bazy, koloru i topu zamiast jednej bardzo grubej.
- Utwardzaj produkty zgodnie z czasem zalecanym przez producenta i mocą swojej lampy.
- Obfitą warstwę lepką w razie potrzeby usuń cleanerem technicznym i delikatnie zmatowij przed kolejnym krokiem.
- Przypominaj klientce, że po wyjęciu dłoni z lampy nie powinna dotykać paznokci ani smarować rąk kremem.
Warto też wyjaśnić klientom jeden częsty mit: nie istnieje coś takiego jak „warstwa dyspersyjna paznokcia”. Lepkość, z którą pracujesz, zawsze pochodzi z produktów stylizacyjnych, a nie z naturalnej płytki. Taka wiedza buduje zaufanie i pokazuje, że świadomie zarządzasz procesem manicure.